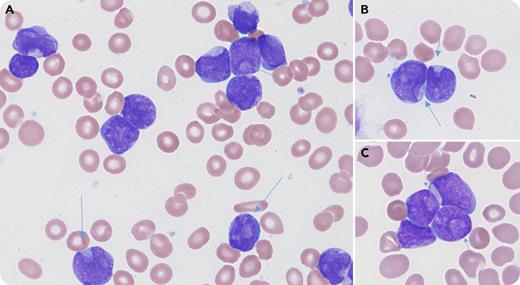
A 7-year-old previously healthy girl presented with fever, fatigue, and weight loss for 1 month. Laboratory test revealed normocytic anemia (hemoglobin, 7.1 g/dL), neutropenia (0.17 × 109/L), and 30% small- to medium-sized blasts with frequent (20%) cuplike nuclei (panels A-C, arrows; Wright’s stain, original magnification ×1000) in peripheral blood. Flow cytometry analysis revealed CD19+CD10+CD34+TDT+ blast population consistent with precursor B-cell acute lymphoblastic leukemia (B-ALL). Conventional cytogenetic study revealed a normal karyotype. Fluorescence in situ hybridization analysis revealed IKZF1 deletion. Microarray confirmed IKZF1 loss as the only cytogenetic aberration. She was started with induction chemotherapy per AALL0932 as standard risk B-ALL. At the end of induction, bone marrow showed 0.05% minimal residual disease by flow cytometry. Then her treatment was intensified to high risk protocol (AALL1131). She achieved complete remission after intensification chemotherapy. / Cuplike nuclear morphology is well recognized in acute myeloid leukemia and is frequently associated with a normal karyotype, as well as FLT3-ITD and/or NPM1 mutations. Cuplike nuclear morphology is uncommon in ALL, with only rare cases reported, including one Philadelphia chromosome–positive B-ALL and one B-ALL with TP53 and DNMT3A mutations. Its clinical significance and association with cytogenetic/molecular abnormalities in ALL are unknown.

A 7-year-old previously healthy girl presented with fever, fatigue, and weight loss for 1 month. Laboratory test revealed normocytic anemia (hemoglobin, 7.1 g/dL), neutropenia (0.17 × 109/L), and 30% small- to medium-sized blasts with frequent (20%) cuplike nuclei (panels A-C, arrows; Wright’s stain, original magnification ×1000) in peripheral blood. Flow cytometry analysis revealed CD19+CD10+CD34+TDT+ blast population consistent with precursor B-cell acute lymphoblastic leukemia (B-ALL). Conventional cytogenetic study revealed a normal karyotype. Fluorescence in situ hybridization analysis revealed IKZF1 deletion. Microarray confirmed IKZF1 loss as the only cytogenetic aberration. She was started with induction chemotherapy per AALL0932 as standard risk B-ALL. At the end of induction, bone marrow showed 0.05% minimal residual disease by flow cytometry. Then her treatment was intensified to high risk protocol (AALL1131). She achieved complete remission after intensification chemotherapy.
Cuplike nuclear morphology is well recognized in acute myeloid leukemia and is frequently associated with a normal karyotype, as well as FLT3-ITD and/or NPM1 mutations. Cuplike nuclear morphology is uncommon in ALL, with only rare cases reported, including one Philadelphia chromosome–positive B-ALL and one B-ALL with TP53 and DNMT3A mutations. Its clinical significance and association with cytogenetic/molecular abnormalities in ALL are unknown.
A 7-year-old previously healthy girl presented with fever, fatigue, and weight loss for 1 month. Laboratory test revealed normocytic anemia (hemoglobin, 7.1 g/dL), neutropenia (0.17 × 109/L), and 30% small- to medium-sized blasts with frequent (20%) cuplike nuclei (panels A-C, arrows; Wright’s stain, original magnification ×1000) in peripheral blood. Flow cytometry analysis revealed CD19+CD10+CD34+TDT+ blast population consistent with precursor B-cell acute lymphoblastic leukemia (B-ALL). Conventional cytogenetic study revealed a normal karyotype. Fluorescence in situ hybridization analysis revealed IKZF1 deletion. Microarray confirmed IKZF1 loss as the only cytogenetic aberration. She was started with induction chemotherapy per AALL0932 as standard risk B-ALL. At the end of induction, bone marrow showed 0.05% minimal residual disease by flow cytometry. Then her treatment was intensified to high risk protocol (AALL1131). She achieved complete remission after intensification chemotherapy.
Cuplike nuclear morphology is well recognized in acute myeloid leukemia and is frequently associated with a normal karyotype, as well as FLT3-ITD and/or NPM1 mutations. Cuplike nuclear morphology is uncommon in ALL, with only rare cases reported, including one Philadelphia chromosome–positive B-ALL and one B-ALL with TP53 and DNMT3A mutations. Its clinical significance and association with cytogenetic/molecular abnormalities in ALL are unknown.
For additional images, visit the ASH Image Bank, a reference and teaching tool that is continually updated with new atlas and case study images. For more information, visit http://imagebank.hematology.org.